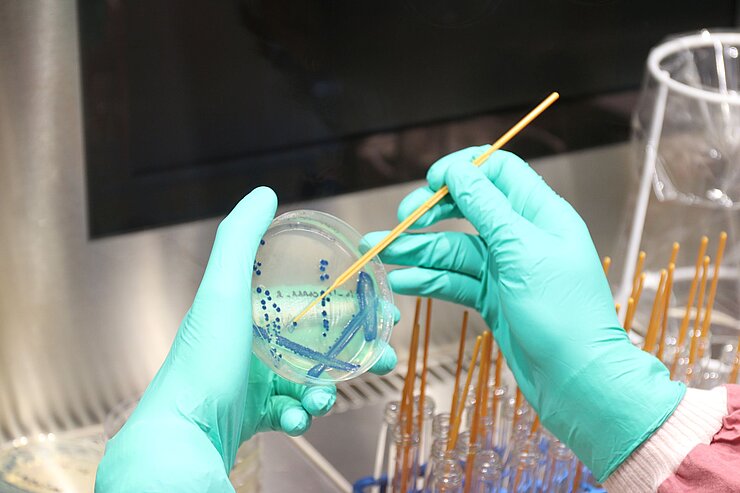
Bacteria spread on an agar plate

Epidemiology and Ecology of Antimicrobial Resistance

Our Research

Antimicrobial resistance (AMR) is an increasing threat to public health. Many antibiotics, indispensable tools in the fight against bacterial infectious diseases, are losing their effectiveness as different and novel multi-drug resistant pathogens are on the rise. AMR arises naturally through mutations in the genes of the bacteria to be combated - and can be transferred between microbes through horizontal transfer of resistance genes. As antibiotics are routinely and excessively used to fight bacterial infections in both humans and animals, and the transfer of bacteria between these hosts is common, increasing antibiotic resistance can be observed. In addition, the use of antibiotics in veterinary and human medicine can have an impact on bacteria and AMR in the environment and on wildlife, e.g. through pollution of water bodies. The interdependencies between AMR in humans, animals and the environment as well as the rapid spread potential of AMR between bacterial species make a One Health approach essential to tackle this urgent global problem. One of the questions we address is how antibiotic resistance develops and spreads. Among other things, we are dedicated to the question of how antibiotic resistance develops and spreads. Our work includes not only the identification and classification of classical resistances and their epidemiological evaluation, but also the in-depth investigation of bacterial virulence and fitness factors, such as the formation of bacterial biofilms, as well as the establishment of alternative therapeutic strategies. With the help of genotypic and phenotypic experiments as well as functional and phylogenetic genome and transcriptome analyses, our primary goal is to analyze, better understand and ultimately combat successful pandemic pathogens.
Our Research
Antimicrobial resistance (AMR) is an increasing threat to public health. Many antibiotics, indispensable tools in the fight against bacterial infectious diseases, are losing their effectiveness as different and novel multi-drug resistant pathogens are on the rise. AMR arises naturally through mutations in the genes of the bacteria to be combated - and can be transferred between microbes through horizontal transfer of resistance genes. As antibiotics are routinely and excessively used to fight bacterial infections in both humans and animals, and the transfer of bacteria between these hosts is common, increasing antibiotic resistance can be observed. In addition, the use of antibiotics in veterinary and human medicine can have an impact on bacteria and AMR in the environment and on wildlife, e.g. through pollution of water bodies. The interdependencies between AMR in humans, animals and the environment as well as the rapid spread potential of AMR between bacterial species make a One Health approach essential to tackle this urgent global problem. One of the questions we address is how antibiotic resistance develops and spreads. Among other things, we are dedicated to the question of how antibiotic resistance develops and spreads. Our work includes not only the identification and classification of classical resistances and their epidemiological evaluation, but also the in-depth investigation of bacterial virulence and fitness factors, such as the formation of bacterial biofilms, as well as the establishment of alternative therapeutic strategies. With the help of genotypic and phenotypic experiments as well as functional and phylogenetic genome and transcriptome analyses, our primary goal is to analyze, better understand and ultimately combat successful pandemic pathogens.
Prof. Dr. Katharina Schaufler, PhD
My research interests lie not only in the elucidation of fundamental mechanisms for the development and transmission of multidrug resistance, but also in the development of alternative strategies to combat antibiotic-resistant pathogens. In my area of responsibility, I am committed to ensuring that future generations continue to have access to effective antibiotics.

In 2016, veterinarian and microbiologist Katharina Schaufler obtained her doctorates (Dr. med. vet. and PhD) on the topic of antibiotic resistance under the expert supervision of Professor Lothar H. Wieler at the Free University of Berlin. Her academic journey in the context of an Alexander von Humboldt Research Fellowship took her to Harvard Medical School in Boston, where she gained valuable experience under the guidance of Professor Michael S. Gilmore. As a microbiologist, she was appointed Junior Professor of Pharmaceutical Microbiology at the University of Greifswald in 2019 and successfully acquired the BMBF junior research group "DISPATch_MRGN" in November 2020, which is endowed with over two million euros. In 2021, she accepted the call to the Christian-Albrechts-Universität zu Kiel, where she dedicated herself to medical microbiology. Since mid-2023, she has been Head of the Department “Epidemiology and Ecology of Antimicrobial Resistance” at the Helmholtz Institute for One Health, as well as a professor at University Medicine Greifswald.
Katharina Schaufler is an experienced scientist in the field of antimicrobial resistance and is an integral part of an international network of experts. Her research activities are part of the holistic One Health approach, which uses state-of-the-art bioinformatics and molecular biology methods to pursue the overarching goal of taking a comprehensive view of human, animal and environmental health. The focus is not only on the elucidation of fundamental mechanisms for the development and transmission of infectious diseases, but also on the development of alternative strategies to combat antibiotic-resistant pathogens. To realize her research vision, she successfully acquires a large number of third-party funded projects, wins prizes and publishes her scientific findings in renowned journals.
Selected Publications
Schaufler K, Schmidt N, Schwabe M, Heiden SE, Fickenscher H, Who PY, Tien SB, Velavan TP, Song LH, Neumann B, Idelevich EA, Becker K, Krumbholz A, Kocer K, Boutin S, Nurjadi D, Eger E. Rethinking virulence screening in Klebsiella pneumoniae: A case for a standardized Galleria mellonella infection model. The Lancet Microbe. 2026
Müller JU, Eger E, Jana B, Schwabe M, Nurjadi D, Ma Y, Pirolo M, Guardabassi L, Schaufler K. The hidden link between cefiderocol resistance and increased virulence in Klebsiella pneumoniae: insights from a transposon-directed insertion-site sequencing-based investigation. Clin Microbiol Infect. 2026. 32(4):603-609. DOI: 10.1016/j.cmi.2025.12.010
Lübcke P, Heiden SE, Homeier-Bachmann T, Bohnert JA, Schulze C, Eger E, Schwabe M, Guenther S, Schaufler K. Multidrug-resistant high-risk clonal Escherichia coli lineages occur along an antibiotic residue gradient in the Baltic Sea. npj Clean Water. 2024. 7:94. DOI: 10.1038/s41545-024-00394-7
Shaidullina ER*, Schwabe M*, Rohde T, Shapovalova VV, Dyachkova MS, Matsvay AD, Savochkina YA, Shelenkov AA, Mikhaylova YV, Sydow K, Lebreton F, Idelevich EA, Heiden SE, Becker K, Kozlov RS, Shipulin GA, Akimkin VG, Lalk M, Guenther S, Zautner AE, Bohnert JA, Mardanova AM, Bouganim R, Marchaim D, Hoff KJ, Schaufler K*, Edelstein MV*. Genomic analysis of the international high-risk clonal lineage Klebsiella pneumoniae sequence type 395. Genome Med. 2023. 15(1):9. DOI: 10.1186/s13073-023-01159-6
Heiden SE*, Hübner NO*, Bohnert JA, Heidecke CD, Kramer A, Balau V, Gierer W, Schaefer S, Eckmanns T, Gatermann S, Eger E, Guenther S, Becker K, Schaufler K. A Klebsiella pneumoniae ST307 outbreak clone from Germany demonstrates features of extensive drug resistance, hypermucoviscosity, and enhanced iron acquisition. Genome Med. 2020. 12(1):113. DOI: 10.1186/s13073-020-00814-6





